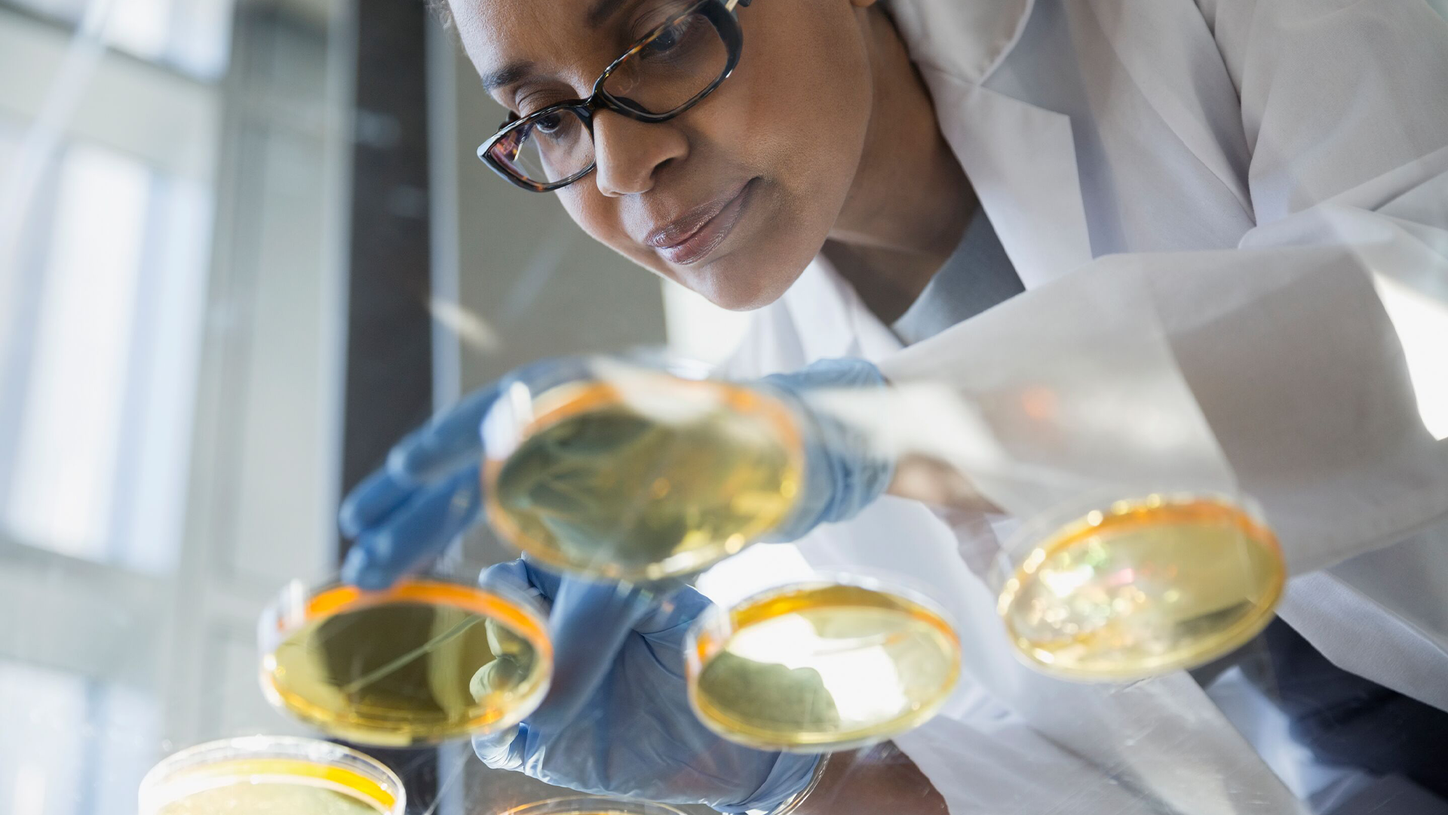
Damos passos ousados

Enquanto líder em tecnologia médica, queremos impulsionar um mundo onde os avanços na área da saúde criem novas possibilidades com o mínimo impacto no nosso planeta. Ao disponibilizarmos constantemente soluções inovadoras no mercado, capacitamos os profissionais de saúde a inovar nos cuidados personalizados, a alcançar a excelência operacional e a transformar o sistema de saúde.
O nosso portfólio, que abrange desde diagnósticos in vitro e in vivo a soluções de terapia guiada por imagem e cuidados oncológicos, é essencial para a tomada de decisões clínicas e vias de cuidados de saúde. Dado o nosso distintivo posicionamento de mercado nas áreas de patient twinning (gémeo digital), terapia de precisão, e inteligência artificial, digital e de dados, estamos preparados para enfrentar os desafios do setor da saúde. Continuaremos a desenvolver estes pontos fortes para ajudar a combater as doenças mais ameaçadoras a nível global, melhorando a qualidade dos resultados e viabilizando um maior acesso aos cuidados de saúde.
Em Portugal, já somos 467 Healthineers, e a nossa equipa continua a crescer! Trabalhamos todos os dias lado a lado com instituições de saúde para tornar possível um diagnóstico mais precoce, tratamentos mais eficazes e melhores resultados para os pacientes. Com soluções inovadoras em imagiologia médica, diagnóstico e saúde digital, queremos impulsionar a transformação digital do sistema de saúde português e contribuir para um futuro mais humano, próximo e sustentável.
No mundo, somos uma equipa constituída por mais de 72.000 Healthineers, presente em mais de 70 países, que desafia diariamente os limites da prestação dos cuidados e serviços de saúde, com o objetivo de melhorar a vida das pessoas em todo o mundo.
Os Nossos Valores
Informações Gerais
Projetos Nacionais
Ao longo dos anos, temos participado ativamente em diversos projetos nacionais que refletem o nosso compromisso com a inovação, a colaboração e o desenvolvimento sustentável do setor. Cada iniciativa representa uma oportunidade de aplicar o nosso conhecimento e tecnologia em prol do progresso do país, contribuindo para melhorar processos, impulsionar a transformação digital e gerar valor para organizações, profissionais e comunidades.

Great Place to Work
A Siemens Healthineers é distinguida com a certificação Great Place to Work®, um reconhecimento que reflete a nossa cultura organizacional assente na confiança, colaboração e desenvolvimento contínuo. Este certificado atesta o compromisso da empresa em proporcionar um ambiente de trabalho inclusivo, inovador e motivador, onde cada colaborador tem espaço para crescer, contribuir e sentir-se valorizado.